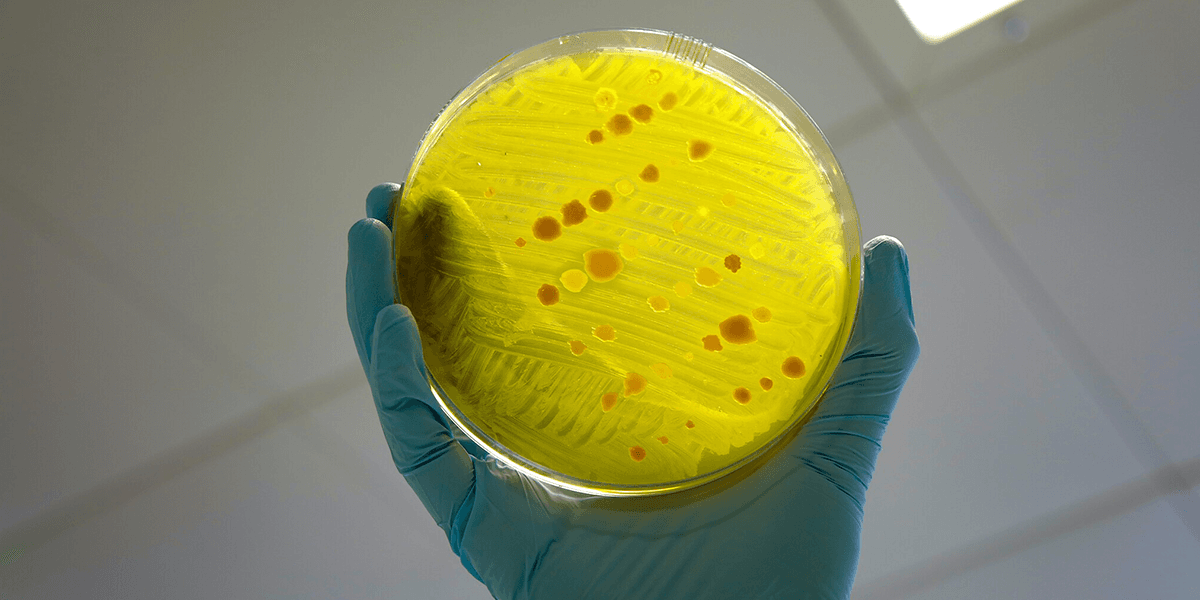

En ny studie från Göteborgs universitet visar att svenska konsumenter är beredda att betala avsevärt mer för antibiotika som produceras med tydliga miljökrav. Samtidigt ser vi en snabbt växande antibiotikakris som kräver politiskt ledarskap i EU.
Antibiotikakris: Sju miljoner döda men ingen plan för framtiden

Mest läst i kategorin
Kombinationen av stark betalningsvilja, svag lagstiftning och ett tilltagande globalt hot sätter press på både marknad och beslutsfattare.
”Sju miljoner människor om året dör av bakterieinfektioner i världen. Det är den näst största dödsorsaken efter hjärt-kärlsjukdomar”, säger Otto Cars, professor emeritus vid Uppsala universitet.
Konsumenterna redo att betala
I en webbenkät till drygt 2 000 personer uppgav deltagarna att de i genomsnitt kan lägga cirka 140 kronor extra på en antibiotikakur som uppfyller miljökrav. Det motsvarar en prishöjning på över 60 procent.
Alternativt accepterade de en årlig skatt på drygt 75 kronor som skulle möjliggöra en statlig subvention om omkring 165 kronor per behandling.
Cirka 80 procent av deltagarna var positiva till minst ett av alternativen. Studien, publicerad i Ecological Economics, prövade två modeller. En miljömärkning med högre slutpris och en statlig subvention finansierad via antibiotikaskatt.
Professor Joakim Larsson, föreståndare för Centrum för antibiotikaresistensforskning, Care, vid Göteborgs universitet, betonar vikten av kollektiv finansiering. Han säger i en artikel i Läkemedelsvärlden:
”I grunden handlar det om ett kollektivt ansvarstagande för en gemensam resurs, fungerande antibiotika. Det är inte rimligt att valet mellan en billigare och en dyrare produkt ska avgöra vem som bidrar. Hela samhället bör stå för detta, till exempel genom skatt.”
Senaste nytt
Regleringsglapp och försenad svensk miljöpremie
Aktiva substanser tillverkas ofta i fabriker i Asien där utsläppskrav är otillräckliga. Vilket driver resistensutveckling och medför risk för global spridning. Forskare framhåller att tvingande lagstiftning med sträng kontroll vore mest effektiv. Men politiska initiativ har hittills strandat, ett indiskt lagförslag stoppades 2020 efter industriprotester.
I Sverige är den planerade fyraåriga försöksverksamheten med miljöpremie försenad. Läkemedelsverkets utredare Krister Halldin skriver i Läkemedelsvärldens artikel:
”Jag får tyvärr meddela att försöksverksamheten med miljöpremien inte är startad ännu. Vi myndigheter inväntar att regeringens förordning som styr försöksverksamheten skall bli klar. Men har i dagsläget ingen uppdaterad information från departementet om hur tidsramarna ser ut.”
Antibiotikakris med ökande oro och krav på EU
Hösten 2024 fanns en försiktig optimism efter FN:s högnivåmöte där länderna enades om att minska antalet dödsfall kopplade till antibiotikaresistens med tio procent till 2030. Ett år senare har tonläget skiftat.
Otto Cars, professor emeritus vid Uppsala universitet och medgrundare av React, ser utvecklingen som djupt oroande. Han säger i en intervju publicerad i Läkemedelsvärlden:
”Läget är väldigt allvarligt nu och utvecklingen går på alla sätt åt fel håll. Sju miljoner människor om året dör av bakterieinfektioner i världen. Det är den näst största dödsorsaken efter hjärt-kärlsjukdomar. Antibiotikaresistenta infektioner beräknas orsaka nära 40 miljoner dödsfall under de kommande 25 åren.”
Som lösning på världens snabbt växande antibiotikakris efterlyser Cars en ny forskningsstrategi och större långsiktig finansiering.
”Här är det pinsamt att EU som på flera sätt visat stort politiskt engagemang i antibiotikafrågan ändå inte lyckas få bort den antibiotikaanvändning utan recept som förekommer i flera EU-länder.”
Om nya terapeutiska spår kommenterar han:
”Det är jättebra att det kommer sådana framsteg, men problemet är att det saknas samhälleligt och politiskt ansvarstagande för att bära dessa och andra projekt vidare.”
Han pekar på ett bräckligt system där stora läkemedelsbolag lämnat fältet, medan universitetsgrupper och små bolag har kortsiktig finansiering.
Bindande global uppgörelse och europeiskt ansvar
Med USA:s reträtt från centrala globala hälsoåtaganden behöver EU kliva fram, menar Cars i intervjun. Tillsammans med Göran Tomson argumenterar han för en global, bindande överenskommelse med samma tyngd som Parisavtalet. En överenskommelse där ett avtal säkrar transparent övervakning, internationellt samarbete, finansiering för prevention och innovation samt tydliga regelverk för ansvarsfull användning och rättvis tillgång. De förespråkar även en global fond som stöttar resurssvaga länder.
I december är det 80 år sedan penicillinet belönades med Nobelpriset. Cars konstaterar i Läkemedelsvärldens artikel:
”Det är sorgligt och obegripligt att världen inte har förstått hur man ska använda en sådan resurs som antibiotika”, och han avslutar med en uppmaning, ”Nu krävs politiskt nytänkande för att vända antibiotikakrisen, vi kan inte vänta på nästa politiska deklaration 2029.”
Fakta – därför spelar betalningsviljan roll
-
-
- Cirka 80 procent positiva till miljömärkning eller subvention, betalningsvilja i snitt cirka 140 kronor per kur.
- Alternativ modell: Årlig skatt på drygt 75 kronor möjliggör subvention om cirka 165 kronor per behandling.
-
Regleringsglapp: Svaga utsläppskrav i tillverkande länder driver resistens, politiska initiativ har strandat.
-
Svenskt pilotprojekt: Miljöpremie för föroreningssnål produktion är försenad i väntan på förordning.
-
Globalt läge: Sju miljoner dör årligen av bakteriella infektioner enligt Otto Cars, resistenta infektioner kan kosta nära 40 miljoner liv på 25 år.
-
Policyspår: EU-ledarskap och ett bindande globalt avtal efterlyses, inklusive fond för rättvis tillgång och omställning.
-
Källa: Läkemedelsvärlden, Åtta av tio vill betala extra för att bromsa resistens samt ”Nu måste ledarskap snabbt fram i EU”, oktober 2025
Läs mer: Medellivslängd tillbaka på nivåer före pandemin, men här ökar dödligheten Dagens PS

Erfaren projektledare och skribent med bakgrund inom Content Marketing. Skriver idag främst Weekend-material för Dagens PS.

Erfaren projektledare och skribent med bakgrund inom Content Marketing. Skriver idag främst Weekend-material för Dagens PS.

Elektrifiera vardagen med upp till 12 mils färd helt på el. Välj en SWE Edition fullpackad med utrustning till ett förmånligt pris och lågt förmånsvärde.